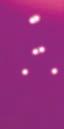

![]()




































































































































































































Depois de abrir filiais da BrackLaw no Brasil (Rio de Janeiro e Rio Grande do Sul), Framingham, em Massachusetts, agora o advogado Danilo Brack abriu um escritório em Orlando, na Flórida.



Brack, que é considerado um dos mais experientes em questões imigratórias na comunidade brasileira nos Estados Unidos, destaca que a



recebo semanalmente de pessoas na região, às vezes até ao vivo em entrevistas que faço frequentemente”, disse.

A ideia, de acordo com Brack, é aproximar os seus serviços ao cliente que tem necessidades na área de imigração.


abertura de novas filias tem ajudado mais brasileiros.


O telefone, no momento, continua o mesmo, (978) 453-7225, para clientes nos EUA e contatos também podem ser feitos pelo e-mail info@bracklaw. com ou pelo website www.Bracklaw.com
O novo endereço está localizado no 618 E South Street, Suite 500, Orlando, FL atender pessoalmente

meros pedidos que mês. “Quero aumentar o contato com nosso público brasileiro nas comunidades da Flórida, e é na realidade uma resposta aos inú-



















































































OE-mail: (opinião/opinion) news@braziliantimes.com (anúncio/marketing) ad@braziliantimes.com
EDIRSON PAIVA Publisher STAFF NEWS









Notáveis USA é um dos eventos mais importantes direcionados a homenagear os brasileiros que vivem fora do fazem a diferença em suas comunidades. O evento, idealizado e organizado pela Brazilian Community Heritage Foundation dividido em três partes: indicação, votação e entrega dos troféus. Destas, as duas primeiras contam com o dos internautas.




EDIRSON PAIVA JR. Chief Editor
CRISTINA PAIVA
Finance Director























Brasil e e organizado , é dividido em três partes: apoio














LUCIANO SODRÉ Assistant Editor
CORRESPONDENTS IN BRAZIL
Claudia Carmo São Paulo, SP
Albertina Moura
Belo Horizonte, MG
COLUMNISTS
Arilda Costa (New York)
Marisa Abel (NewYork)
Gisele Cadamuro (Mt. Vernon, NY)
Claudia Cascardo (Newark, NJ)
Lucy Rodrigues (South Carolina)
Marcia Davidowski (Arizona)
Claudia Ramalho (Philadelphia)
Bibi (Newark, NJ)











Francisca Benvenuto (NY)
Patricia Peixoto (Chicago, IL)
JOURNALIST
Camila Oliveira
Selma Kamim (São Paulo - BR)
MARKETING DEPARTMENT



A comissão organizadora disponibiliza um período para que as comunidades indiquem quem elas querem que recebam a homenagem.





Após





votos,

ção. Ao final, eles são quantidade de votos
isso, seguindo as regras do evento, são determinados os nomes que estarão no processo de votação. Ao final, eles são divididos em três categorias baseadas na quantidade de votos que obtiveram.


Liliane Paiva
Daniele Deghi
Patty Peixoto
Jane Bencke
GRAPHIC DESIGNER Everson Menezes


O Estado da Flórida lidera com 276. 863 votos, se- guido por Massachusetts com 90.839, e Illinois com 90.340.



O site já registrou mais de um milhão e meio de acessos, desde o começo da votação, em 10 de janeiro.
DIRECTOR OF PHOTOGRAPHY Paulo Lopes
EVENTS COORDINATOR Daniele Deghi & Liliane Paiva
CIRCULATION DEPARTMENT
Christiane Paiva
Valéria Guinancio
José Joaquim Guimarães
MAILING ADDRESS
Brazilian Times P.O.Box 447 Somerville, MA 02143
Os artigos assinados e/ou colunas e cartas, são de responsabilidades de se- autores e não refletem, necessariamente, a opinião






































































Notable Brazilian Award, ou Notáveis USA, é uma iniciativa que visa homenagear brasileiros que se destacam em suas áreas de atuação, contribuindo de forma significativa para o desenvolvimento dos Estados Unidos e alguns países.


O prêmio foi criado em 2011 e é organizado pela Brazilian Community Heritage Foundation (BCHF). A cerimônia de premiação acontece anualmente em New York e conta com a presença de autoridades, líderes empresariais, religiosos, artistas e outras personalidades.
Os premiados são escolhidos por meio de um processo de indicação e posteriormen-










te votação. Em ambos, a comunidade tem uma participação importante.
O evento deste ano vai acontecer no dia 02 de setembro, no NYC Event Center, localizado no 4W 43rd Street, Manhattan (NY).
Para reservar um convite ou obter mais informações, ligue no telefone 1-877-6250079.



























































2022 - 2023

APRESENTAÇÃO




MÚSICA







Raysa Shesuê apresentadora

PARTICIPAÇÃO ESPECIAL

















Sergio Buq Cantor










































































Sua Majestade Real, a Rainha Angelique-Monet, a Rainha Consorte de Eti-Oni, Estado de Osun, Nigéria, confirmou a participação no Notable Brazilian Awards deste ano. O evento acontece em New York e homenageia brasileiros em todo o mundo.
Nascida na América, a rainha da beleza que se tornou a rainha consorte da mais antiga plantação de cacau da Nigéria retorna à sua terra natal para uma turnê real, o primeiro compromisso oficial dos Estados Unidos agora com o título Sua Majestade Real Rainha Angelique-Monet de Eti-Oni, Sua Majestade Yeyeluwa Olori de Eti-Oni e forma abreviada Rainha Angelique-Monet Em um esforço para apoiar o marido e o trabalho de longa data do rei, a rainha


Angelique-Monet é uma defensora das mulheres rurais em comunidades produtoras de cacau como Eti-Oni, onde a tecnologia digital e o suporte, incluindo serviços sociais como saneamento e serviços de saúde, a igualdade de gênero e o acesso à internet são limitados.
Como uma















































Festivals



africano e em uma cidade rural, a rainha Angelique-Monet também trabalha como presidente do Grupo de Desenvolvimento Eti-Oni, envolvendo todos os parceiros de desenvolvimento, o que lhe dá experiência prática e uma compreensão clara dos aspectos práticos e soluções viáveis que podem ser oferecidas ou empregadas para alcançar os resultados desejados. Em seu discurso, ela deu as razões pelas quais ONGs menores e parcerias são essenciais para enfrentar e abordar os vários problemas mencionados anteriormente e aproveitou a oportunidade para dar as boas-vindas a todos que visitam o Reino de Eti-Oni para conhecer os produtores de cacau, principalmente mulheres, e vivenciar um comunidade rural produtora de cacau localizada na floresta tropical.



Para a rainha Angelique-Monet, sua organização, NGIA
AFIWPI também usa filmes, mídia e smartphones para





nas

jornalismo cidadão para abordar questões importantes, enquanto trabalha em parceria com a International Cocoa Diplomacy fundada por Sua Majestade Real Oba (Rei) Dokun Thompson, seu marido e ambos fundaram o único festival de cinema na Nigéria que acontece duas vezes por ano e focado nas comunidades rurais - Royal Cocoa International Film Festivals com objetivos de levar o cinema internacional às comunidades rurais, incluindo treinamento em técnicas de produção de filmes para que as pessoas rurais possam começar a desenvolver e compartilhar suas histórias através da tecnologia.
de produção de filmes para que as conhecida como ‘’Rainha Ventrílo-
desenvolver e compartilhar suas
A Rainha Angelique-Monet ficou conhecida como ‘’Rainha Ventríloqua’’ e ‘’Royal Puppet Performer’’ pela BBC Focus on Africa, tendo se tornado notícias, pois sua história acaba parecendo um conto de fadas da vida real, onde a rainha da beleza se casa com um dos reis mais progressistas do continente africano, Sua Majestade o Oloni de Eti-Oni, Oba (Rei) Dokun Thompson Gureje IV.
se tornado notícias, pois sua história acaba parecendo um conto de
mais progressistas do continente reino majestoso e exótico e tra-
Assim, mudando-se para seu reino majestoso e exótico e trazendo seu fantoche, muitas vezes realizando atos de ventriloquismo para as crianças. O Reino de Eti-Oni é uma cidade rural localizada no cinturão da floresta tropical da África Ocidental Subsaariana no estado de Osun e é a plantação de cacau mais antiga da Nigéria. Os Notáveis USA acontecerá no dia 02 de setembro, no NYC Event Center, em Manhattan (New York).
Para mais informações, ligue no telefone 1-877-6250079.




















































Os Notáveis USA, nome mais popular do Notable Brazilian Awards, vai acontecer no mês de setembro em New York e várias pessoas já confirmaram presença. Inclusive algumas personalidades brasileiras.






Entre elas a atriz Mariza Marchetti, que possui um vasto trabalho no Brasil em vários filmes para a televisão e cinema, além de dezenas de peças teatrais.

Em 1998 Marisa ingressou na faculdade de Direito pela Universidade Paulista (UNIP), formando-se em 2002. Também em 2002 realizou o curso de Artes Cênicas na Incenna Escola de Teatro e Televisão.
















ca, Além de Dois, Vida a Três e Noturno. Em 2009 assinou com o portal Spetáculos e teve sua primeira experiência com a internet protagonizando a web-novela Vento Norte como a sofredora Raíssa, passando no mesmo ano para o posto de antagonista em Black Tie, como a ambiciosa Micaella L’faire. Em 2012 esteve no elenco de Máscaras, na Rede Record, interpretando a ginecologista Paula Aguillar.

Em 2013 integra o elenco de Flor do Caribe, da Rede Globo, como a médica Márcia, que mantinha uma ONG para tratar de crianças e adolescentes que sofriam exploração sexual. Em 2016 tem a oportunidade de interpretar seu primeiro papel de destaque, Lady Rebeca em Escrava Mãe, uma abolicionista que lutava pela emancipação da mulher. Em 2017 interpretou Malca em O Rico e Lázaro.


Em 1998 Mariza teve sua primeira experiência na televisão narrando o episódio piloto do seriado Mulher. Em 2000 estreou como atriz na minissérie Tele-Tema, do canal por assinatura TVC Rio, interpretando a estudante Carla. Em 2002 esteve na telenovela Marisol como Raquel, secretária da personagem principal, além de participar do documentário Raul Roulien, um Brasileiro em Hollywood.








Nos anos seguintes fez participações especiais nas novelas Seus Olhos e Revelação, além de estar no elenco dos curtas-metragens Nostra Bella Épo-




A outra personalidade confirmada é o Dr Rildo Lasmar, o cirurgião dentista brasileiro de Goiás, que conquistou o mundo. Ele formou-se em 1996 pela UNIUBE – Universidade de Uberaba, com especialidade e Mestre em Implantodontia, Ortodontia, Dentística Estética e Saúde Pública. Igualmente, é membro da ADA (American Dental Association); SBOE (Sociedade Brasileira de Odontologia Estética); ABOR (Associação Brasileira de Ortodontia); FDI (World Dental Federation); ABOE (Academia Brasileira de Odontologia Estética); ABO (Associação Brasileira de Odontologia) e AACD (American Academy of Cosmetic Dentistry). Além, também, de possuir mais de 300 cursos no Brasil e no exterior.
Ele conta com centenas de milhares de seguidores nas redes sociais.






























































No dia 02 de setembro vai acontecer em Manhattan, New York, o XIII Notable Brazilian Awards, conhecido como Notáveis USA, o evento que homenageia brasileiros nos Estados Unidos e em outros países. Entre os homenageados estarão jornalistas, empresários, artistas, profissionais liberais, líderes políticos e religiosos, personalidades entre outros.

No evento deste ano estão confirmadas as cantoras Joanna Nova York, Farah Crespo, o saxofonista Gilton Martinez. Como apresentação principal foi convidado o cantor Sérgio Buq, que tem uma grande ligação e história com a música popular brasileira.
A apresentação estará sob o comando de Amadeu Maya (Mestre de Ce-




















rimônia), George Roberts (Apresentador), Marisa Abel e Rayssa Shesue (Apresentadoras).
Também haverá uma apresentação de arte sob a coordenação da InArt Café.
O Notáveis USA é uma produção da Classic Produção, Realização da Brazilian Community Heritage Foundation, co-realização do Museu do Imigrante Brasileiro.






























Texto: Eliana Marcolino
Elizandra Aguiar é uma empresária de sucesso nos Estados Unidos. Ela é corretora de Imóveis no Estado da Flórida. Recebeu premiação de destaque no ano de 2022 pelo seu impressionante volume de casas vendidas em um único ano. A sua especialidade é casas de férias no seleto seguimento das luxuosas mansões. A corretora tem motivo de sobra para comemorar, nos últimos meses tem aumentado exponencialmente a procura por grandes investidores e também muitos famosos conhecidos nacional e internacionalmente.
Além de ter conquistado o merca-



























do Norte Americano, Elizandra conquistou clientes na Europa, América do Sul, Canadá e até de Dubai, na Ásia.
Um dos principais motivos que tem atraído a atenção e motivado essa gama de investidores se explica pelo grande crescimento na região Central da Flórida, nas imediações da Disney World. A região se tornou a segunda maior metrópole que mais cresce nos Estados Unidos e também a primeira cidade mais visitada do mundo, desbancando Nova York e Paris.
Elizandra Aguiar é natural de Uberlândia MG. Vive nos EUA







A garra e determinação dessa mulher empreendedora, somada à sua simpatia e amorosidade a torna uma empreendedora diferenciada


há 22 anos. Quando ela se mudou para o estado da Flórida, os parentes, amigos e clientes começaram a procurá-los com o interesse de fazer investimentos em casas de luxo residenciais, principalmente casas de férias. Foi nesse período que Elizandra, em parceria com o esposo Rômulo Aguiar decidiram adquirir as licenças e permites, junto ao Estado da Flórida para atender a essa demanda de forma legal e profissional. Gradualmente o negócio foi crescendo ao ponto de eles receberem premiações pelo reconhecimento do volume de propriedades vendidas no Estado da Flórida e vários outros


A sua especialidade é casas de férias no seleto seguimento das luxuosas mansões
estados da América.
A garra e determinação desta mulher empreendedora, somada à sua simpatia e amorosidade a torna uma empreendedora diferenciada, fazendo-a conquistar clientes em quatro continentes: América do Norte, América do Sul, Europa e Ásia.
contato (857) 800-4159
ElizandraFloridaRealtor@gmail.com
website: crrmove.com
Charles Rutenberg Realty Group, 631 S.Orlando Ave,Suíte 200 Winter Park, FL 32789

Acomunidade brasileira já conta com a Rádio Brazilian Times como um dos melhores meios de entretenimento em Massachusetts e região. Considerada “a voz brasileira que ecoa por toda a América”, ela já conquistou os ouvintes em diversas partes do país. Isso se deve à programação variada que ela oferecer e o grupo seleto de locutores.
Os ouvintes têm à disposição uma programação variada que vai de noticiários à entretenimento infantil, sempre com um diferencial – oferecer o melhor aos brasileiros.
A programação já era transmitida através das redes sociais e agora, ela pode estar com o ouvinte em todos os lugares e momentos. Baixe o aplicativo na loja do seu telefone (Android e iOS) e curta boas músicas e ótimos programas.




Acesse um dos links a seguir para baixar
Android:

https://play.google. com/store/apps/details?id=br.com.webfoxy. radiobraziliantimes
iOS (Apple)
https://apps.apple. com
Radio Brazilian Times - Apps on Google Play

https://play.google.com









































Onde o brasileiro do exterior fica ligado


























“O advogado americano mais brasileiro dos Estados Unidos”

Com mais de três décadas de experiência e escritório em Burlington (MA), conheça o advogado americano que será premiado no Notáveis.
Com mais de três décadas de experiência em processos imigratórios e milhares de casos aprovados, o advogado americano Adam Elman é referência quando o assunto é imigração em Massachusetts. Trabalhando com uma equipe experiente de profissionais brasileiros, com o objetivo de ajudar imigrantes a se legalizarem e assim realizarem seus sonhos na América, Dr. Adam entende a sua responsabilidade como profissional e com muita ética e competência, tem ajudado cada vez mais famílias brasileiras a conquistarem seus objetivos, por isso já é conhecido em meio à maior comunidade brasileira nos EUA, como: “o advogado americano mais brasileiros dos Estados Unidos”. Título que se orgulha: “Fico muito lisonjeado e agradecido com esse reconhecimento, com a preferência e o carinho dos brasileiros, que são um povo que trabalha tão duro para conquistar seus sonhos. É um privilégio poder ajudá-los nessa trajetória de sucesso!”,

afirma Adam.
Com sede na cidade de Burlington (Massachusetts), o escritório Adam Elman Law conta com um amplo estacionamento, um ambiente confortável, além de uma competente equipe de profissionais, que atendem não só em português e inglês, como também espanhol e que tem ajudado o Dr. Adam Elman a obter resultados incríveis nos mais diversos processos de vistos, pedidos de asilo, SIJ e tantos outros. “É realmente um prazer atendê-los e ver a felicidade estampada em seus rostos quando eles recebem a notícia da aprovação de seus processos!!”, comenta Dr. Adam Elman.
Tanto esforço e dedicação em fazer o melhor em cada caso, para que cada vez mais imigrantes conquistem seus sonhos de se legalizarem nos Estados Unidos, fez com que o Dr. Adam Elman recebesse o merecido reconhecimento e fosse indicado ao prêmio Notáveis 2023, promovido pelo jornal Brazilian Times. “Ter este reconhecimento desta comunidade tão acolhedora é maravilhoso! Estou realmente muito feliz e agradecido”, conta Adam.
Adam ainda não fala português, mas arrisca algumas palavras com sua equipe e com seus clientes e, com muita simpatia, demonstra interesse, curiosidade e apreço pela cultura brasileira: gosta da gastronomia e também de boa música. Ele é fã do cantor sertanejo Gusttavo Lima, já foi indicado pela atriz
e apresentadora Antonia Fontenelle no programa “Na Lata” e sempre que possível apoia ações culturais da comunidade brasileira de New England. Não é para menos que cada vez mais o advogado Adam Elman vem conquistando o respeito e a preferência dos imigrantes que residem em Massachusetts, que entendem a necessidade de contratar um advogado experiente e responsável para obterem êxito em seus processos imigratórios.
A revista Brazilian Times bateu um papo com o Dr. Adam Elman, que você confere a seguir:
Como surgiu a ideia de atuar na área de processos imigratórios?
Eu herdei do meu pai a empatia e a paixão por servir ao próximo e percebi que podia exercer isso através do meu trabalho. Quando percebi que havia uma demanda muito grande na área de processos imigratórios, decidi me dedicar a essa área e é isso que tenho feito com muito afinco e determinação, nesses mais de trinta anos.
Você é conhecido pela comunidade brasileira como “o advogado americano mais brasileiro dos EUA”. Como você recebe esse reconhecimento e carinho da maior comunidade brasileira nos EUA?
Eu fico muito feliz e lisonjeado com esse reconhecimento... A comunidade brasileira trabalha duro para ter uma melhor qualidade de vida e poder ajudá-los nessa trajetória de legalização nos Estados Unidos é um privilégio. Tenho muito respeito e gratidão pela preferência e confiança que eles depositam em mim e em minha equipe. Posso afirmar que por todo esse carinho e gratidão, eu também me sinto

assim: “o advogado americano mais brasileiros dos EUA”. (risos)
Quais são os processos mais procurados em seu escritório?
Os mais diversos... Eu e a minha equipe fazemos o nos-
so melhor para trazer os melhores resultados, avaliando e analisando individualmente caso a caso, mas os mais procurados têm sido os vários tipos de vistos, além dos pedidos de asilo e SIJ.
A quem se destina os benefí-

cios do SIJ?
Jovens imigrantes, menores de 21 anos, que tenham sido abandonados por um dos pais. Esse processo tem ajudado milhares de jovens a se legalizarem no país. É uma conquista que pode mudar o futuro de um jovem para sempre.
Quem pode aplicar para o requerimento de asilo?
Pessoas que não podem voltar ao seu país de origem por motivos de ameaça contra a vida.O asilo oferece proteção a estrangeiros que sofreram perseguições no passado ou temem sofrer perseguições no futuro devido a um dos seguintes fatores: perseguição política, sexual, racial, religiosa, ou violência extrema. O pedido de asilo está disponível apenas no primeiro ano após a entrada nos EUA, exceto em circunstâncias muito raras.
Pelo seu trabalho de excelência, você foi o único advogado americano indicado ao prêmio mais popular da comunidade brasileira nos EUA, o “Notáveis”. Como foi receber essa indicação?
Estou realmente muito feliz e agradecido pela confiança e carinho que a comunidade brasileira me recebe... Receber essa indicação é algo que eu não esperava, mas eu vejo como um importante reconhecimento, receber esse prêmio da maior comunidade brasileira nos Estados Unidos. Me traz uma certeza ainda maior que estamos no caminho certo e que o legado de servir com o meu melhor, está sendo cumprido! Não vejo a hora de estar no palco do Notáveis com toda a comunidade brasileira. É um privilégio servi-los e fazer parte da trajetória de conquistas desse povo tão trabalhador! Só tenho a agradecer.

Flavia Leal Beauty School oferece cursos profissionalizantes para diversas áreas da beleza. E você ainda tem a possibilidade de ter o visto de estudante fazendo um curso na Flavia Leal Beauty School, podendo manter seu status imigratório estudando aquilo que você ama.
Fazer parte de um mercado que vive em constante evolução pode parecer difícil, mas não é impossível se você está comprometido com o seu sucesso e tem a preparação certa para isso. Na Flavia Leal Beauty School você ganha esta experiência.

Faça parte desta comunidade de alunas e professores que estão há 12 anos no mercado com credibilidade, responsabilidade educacional e que te proporcionará muito crescimento e destaque profissional!
A Flavia Leal Beauty School se tornou a maior
























escola de beleza dos Estados Unidos e possui unidades em Boston (Massachusetts) e Orlando (Flórida). Os alunos recebem formação em Estética, Manicure, Cabeleireiro e Barbeiro.
As matrículas já estão abertas. Para mais informações siga a escola nas redes sociais: @flavialealbeautyschool.
UNIDADES:

- 7600 Southland Blvd, Suite 102, Orlando, FL; - 20 Chelsea Street, Everett, MA;
- 36 Cummings Park, Wo-














burn, MA






- 63 Fountain Street, Framingham, MA
TELEFONE:
1(407) 750-7276
(781) 995-4009
E-mail: orlando@flavialeal.com
















































































































O evento foi super badalado com presenças marcantes da comunidade brasileira de Philadelphia








e sua mãe Irineia, duas lindas esbanjando beleza















sua

e suas melhores amigas antes da apresentação de dança mais esperada da festa



A família e os amigos se esbanjaram com a beleza do evento e da aniversariante que arrasou, estava lindíssima, sem contar com sua troca de vestidos maravilhosos. STEPHANNY realmente viveu uma noite de princesa, não faltou charme, elegância e emoção. Sua mãe NÉIA brilhou junto com a filha e não mediu esforços para celebrar essa data tão linda e marcante. Como é linda a relação de mãe e filha: um presente de Deus. MUITA EMOÇÃO!





















































O luxuoso The Regal Ballroom em Philadelphia foi o cenário do aniversário de 16 anos da linda Stephanny.





A decoração estava perfeita nos tons preto e vermelho, super sofisticado. Decoração by Mariana Fernandes @partyandrental
Fotos by Lucas Queiroz @clickstudiojp
DJ MASSA comandou a super festa @djmassausa

































• Atmosfera temática: a Disney cria mundos imaginários detalhados e bem elaborados, desde o Castelo da Cinderela até a cidade de Radiator Springs, para transportar os visitantes para um mundo de fantasia e diversão.
• Personagens icônicos: a Disney criou alguns dos personagens mais amados da cultura pop, como Mickey Mouse, Cinderela, Buzz Lightyear e muitos outros. Esses personagens são frequentemente encontrados nos parques temáticos da Disney, proporcionando oportunidades para fotos e interações inesquecíveis.



ajudar a criar momentos mágicos para os visitantes da Disney.
• Música: a música é um elemento importante em muitos filmes da Disney e nos parques temáticos, criando uma atmosfera mágica e emocional.





Trabalhar no lugar mais mágico da terra é um privilégio ímpar, e quando se tem o orgulho de mostrar e falar que a 10 anos trabalha com isso, é mágico, explica Antonio Gallardo jr.
A magia da Disney é um sentimento que é difícil de descrever com palavras, mas é algo que muitas pessoas experimentam ao visitar um dos parques temáticos da Disney ou ao assistir a um de seus filmes. A magia da Disney é baseada em uma combinação única de elementos, incluindo:
• Excelência no atendimento ao cliente: a Disney é conhecida por sua cultura de excelência no atendimento ao cliente e por se esforçar para criar momentos mágicos para seus visitantes. Os funcionários da Disney, conhecidos como Cast Members, são treinados para serem prestativos, cordiais e criativos para oferecer uma experiência excepcional aos visitantes.
• História: a Disney tem uma rica história de criação de filmes animados inovadores, que se tornaram clássicos atemporais, e de criação de parques temáticos que são considerados marcos na história do entretenimento.
Em conjunto, esses elementos criam uma sensação única de magia que é difícil de replicar em outros lugares. A magia da Disney pode transportar os visitantes para um mundo de fantasia, proporcionar momentos mágicos e duradouros e criar lembranças inesquecíveis.
A Disney valoriza muito seus funcionários e reconhece a importância de sua dedicação e comprometimento. Quando um funcionário da Disney completa 10 anos de trabalho, ele é reconhecido por meio de um programa de comemoração chamado “Disney Traditions”.

Neste programa, os funcionários que completam 10 anos de serviço recebem um certificado comemorativo e uma pequena celebração é realizada para reconhecer a realização. Além disso, os funcionários da Disney também são elegíveis para receber uma série de benefícios adicionais, como planos de saúde, planos de aposentadoria, descontos em lojas da Disney, ingressos para parques temáticos e outras vantagens.
Ser um Cast Member da Disney pode ser uma experiência incrível e gratificante. A Disney é conhecida por sua cultura de excelência no atendimento ao cliente e pela criação de momentos mágicos para seus visitantes, e os Cast Members desempenham um papel fundamental na realização desses objetivos.
Os Cast Members são os funcionários da Disney que trabalham em todas as áreas do parque, incluindo atrações, restaurantes, lojas, hotéis e muito mais. Eles são responsáveis por garantir que os visitantes tenham uma experiência inesquecível na Disney, desde a cordialidade e prestatividade até a execução dos protocolos de segurança e limpeza.
Ser um Cast Member da Disney significa trabalhar em um ambiente animado e interativo, lidando com pessoas de todo o mundo, incluindo visitantes, colegas de trabalho e gerentes. Os Cast Members são encorajados a serem criativos, inovadores e a terem habilidades de comunicação excepcionais para
A Disney acredita que o reconhecimento e a valorização dos funcionários são fundamentais para o sucesso da empresa e, por isso, oferece uma série de programas e benefícios para seus funcionários em todas as fases de suas carreiras. Isso inclui programas de treinamento e desenvolvimento, oportunidades de crescimento e promoção, incentivos de desempenho e muito mais.



O riso é eterno, a imaginação não tem idade, os sonhos são para sempre










Ricardo Martinez
Simone Mocelin cantora Makyra.





Celebrando o primeiro ano da Four Seasons Flower Shop, com o Empresário Tony Linard, Simone Mocelin, Ricardo Martinez e Leidi




























































Feliz aniversário Sibia Keila, aqui com esta colunista Simone Mocelin













































Nova coleção da Disney. Mickey e Minie com detalhes em prata e roxo. Eveline e Simone no Disney Springs , e a







































Casal Renan e Támiris comemorando um ano da Antonella.



Aconteceu dia 14 de Abril a comemoração de 1 ano da Floricultura Four Season Floral and Design, a festa foi animada com música ao vivo com Makyra e Johnnie. O empresário Tony Linard compartilhou que uma vez por mês vai promover Forró, com o intuito de divulgar a cultura nordestina. Novidades vista! Siga no Instagram @4seasonorlando

Novidades na Disney! Iniciou esse mês a nova comemoração nos parques da DisneyThe Walt Disney Company completa os 100 anos de existência no dia 23 de outubro, de 2023. E a festa já começou! Venha se emocionar com esse novo espetáculo.Vem para Orlando conosco! Cuidamos de tudo para você. Info 1+617-9593378 @esmilebrtour Simone Mocelin e Ricardo Martinez




Eu sempre acreditei que Deus nos conecta com pessoas por causa de seus propósitos santos. Propósitos estes que muitas vezes nos são escondidos pela soberania dos céus.
Mas creio que assim a história fica mais linda, pois os mistérios são revelados de acordo com o nosso entendimento e crescimento pessoal e interpessoal. E foi assim que o Senhor uniu a minha casa com a família de minha querida irmã e amiga Aline Barros.

Hoje já passamos de 23 anos de uma conexão com propósitos de Deus, e através dela tive a honra de conhecer e estreitar o relacionamento com seu esposo, Pastor Gilmar! Homem de Deus, sério, ético, e apaixonado pela igreja de Jesus. Juntos forma um casal excepcional!
Amo também ao Pastor Ronaldo (pai da Aline), e sua esposa, a queridíssima Pastora Sandra! Eles são pessoais muito especiais que marcaram nossas vidas!


Certamente ninguém pode negar o privilégio de ter uma pessoa tão ungida, amada, querida, e extremamente talentosa visitando sua igreja por mais de 10 vezes. E sempre com uma experiência nova, e inspiradora. Afinal de contas, quando Deus une pessoas, Ele faz coisas incríveis! Ou seja, o Reino cresce, as pessoas são abençoados, e a comunidade recebe injeção de esperança, alegria, mas sobretudo, recebe a fé que salva!
Além disso, fomos agraciados com a amizade fora do ambiente do culto, pois já viajamos, passeamos, e nos divertimos várias vezes. Minha amiga Aline chama essa conexão de aliança! E como ela está certa sobre isso! Sabemos que o tempo na mesa da comunhão cria laços de amizades permanentes, e reforça a parceira do Reino. Tanto é que quando ela vem em nossas igrejas, seja esta de New York, ou qualquer outra, precisamos buscar somente uma data, pois todas as outras coisas se resolvem naturalmente!
Nos ajuntamos para edificar, capacitar, alegrar, e preparar as pessoas para se encontrarem com o Deus vivo, porque antes de mais nada, a união tem como foco a glória de Deus!

Neste Domingo, dia 26 de Março na Catedral Mount Vernon tivemos um destes encontros marcados no calendário divino. Pessoas foram agraciadas pelos louvores ungidos dela, e pelo testemunho inspirador de seu esposo, Pastor Gilmar!
Estou certo de que todas as pessoas que estiveram presentes têm uma história especial para contar sobre este culto! Não importa a faixa etária, todos foram de alguma forma impactados, tocados, e motivados na fé.
Deus se manifestou na cidade de Mount Vernon através deste culto, e da participação de meus amigos pastores, Gilmar e Aline Barros. A Ele a glória!
Espero que os projetos entre nós sigam firmes e fortes, pois estamos fazendo uma grande obra para Aquele que nos amou primeiro! Servi-lo sempre será o nosso prazer, e fazemos isso de modo intencional, com amor e sinceridade, pois Deus é bom e a sua misericórdia dura para sempre! Pr Wellington Oliveira.
CATEDRAL MOUNT VERNON
114 W. Lincoln Ave, Mount Vernon, NY 10550
Nossos cultos:
Quinta-feira 8Pm | SophiaEscola de Princípios
Sexta-feira 8:30Pm | Upstairs - Encontro Jovem
Domingo 10Am | HallalCulto de Adoração
Informações: 914-714-8149
















Amanda e Rafael, Kalita e Filemon, esses são os dois casais de empreendedores que, juntos, criaram um sonho maior do que eles mesmos ao fundarem a agência de marketing Dream Four Agency
Tudo começou na Primavera de 2022, em uma conferência americana de empresas de limpeza, onde os 4 se conheceram e juntos viram seus negócios individuais renascerem e foram capazes de levá-los ao sucesso em menos tempo do que jamais poderiam imaginar! Amanda e Rafael, com suas empresas de limpeza (Amanda’s Maid) e construção de escadas (Dr.Stairs), localizadas em Charlotte, na Carolina do Norte, começaram do zero a mais de 6 anos atrás, e enfrentaram muitas dificuldades que toda empresa iniciante enfrenta: falta de planejamento, centralização pro-

cessos e organização, falta de investimento em marketing... e tudo acabou virando uma bola de neve que atingiu os dois em cheio.
O mesmo aconteceu com Kalita e Filemon, e sua empresa de serviços de limpeza (WeHa Clean) localizada em West Hartford, Connecticut. Eles tinham um sonho, mas o medo de falhar e os comentários negativos de pessoas ao seu redor os impediram de crescer nos primeiros 4 anos. Foi trabalhando duro e estudando que, individualmente, os quatro tiveram a mesma ideia! Investir em marketing e nos processos de suas empresas!


Juntos, eles compartilharam seus conhecimentos, experiências e sonhos, e viram que ali tinha um verdadeiro “match made in heaven”!
Suas empresas superaram expectativas e atingiram metas que eles só haviam atingido em sonhos. Amanda gerou mais de 1 milhão em vendas, Rafael se tornou referência em sua cidade, e Kalita e Filemon conquistaram a confiança de sua comunidade e foram premiados por isso!
Com tanto su-






cesso, eles então perceberam que possuíam algo gigante em mãos, um conhecimento que poucos possuem, uma ferramenta que pode mudar a vida de mais do que apenas 4 pessoas. Por que não passar isso adiante? Por que não juntar suas individualidades e criar algo impressionante? E assim nasce The Dream Four Agency!
A empresa que busca ajudar empreendedores a alavancar seus negócios através do marketing digital e da contratação de mão de obra qualificada de forma totalmente virtual e fácil! Essa abordagem inovadora em poucos meses já se tornou um sucesso nas comunidades latino-americanas nos Estados Unidos, e vem ajudando pessoas e suas empresas a economizar até 70% em seus negócios. Seus clientes são dos mais variados nichos da indústria, indo de contrução e limpeza (assuntos com os quais eles já são bem familizariados) até beleza e vendas de produtos inovadores no mercado.
Movidos por resultados, cada um tem sua função dentro da empresa baseada naquilo que faz de melhor e que mais ama. A Kalita cuida da parte do branding, enquanto Amanda é responsável pelo setor de vendas, e juntas, elas fazem todo o treinamento de equipes de suas e outras empresas, assim como mentorias personalizadas para donos de negócios.
Filemon é um verdadeiro nerd da tecnologia, e por isso supervisiona








todos os aspectos tecnológicos e sistemas da Dream Four Agency, enquanto o Rafael é o especialista em processos e lidera a área de construção.
O carro chefe da Dream Four Agency são os treinamentos personalizados e exclusivos, como as mentorias para donos de negócios que procuram expandir seus conhecimentos e aprender a delegar e controlar um escritório de maneira 100% online, automatizá-lo, e fazer networking, e também o treinamento intensivo para colaboradores desses escritórios, onde ensinam os princípios sobre a cultura americana (para criar uma conexão e gerar confiança entre a empresa e o consumidor), vendas, marketing, atendimento ao cliente, gestão, e questões operacionais.
O maior sonho de Amanda, Rafael, Kalita, e Filemon é auxiliar outros donos de empresas a alcançarem seus objetivos de crescimento e não passaram pelos obstáculos que eles mesmos tiveram que enfrentar.
Seja mais do que um colaborador de seu próprio negócio, tornese o CEO do seu sonho, administre sua empresa de forma profissional e qualificada. Agora, você não precisa mais fazer tudo sozinho e se questionar se esse é mesmo o caminho que deveria seguir, com The Dream Four Agency, você tem toda a parceria e mentoria que sempre sonhou em ter!
Contatos: +1 (704) 919-9913


Renata Mattos, Filha do Mundo, originalmente nascida em Sao paulo, se mudou para Estados Unidos quando tinha 18 anos onde viveu em Massachusetts por 14 anos, mãe de dois meninos, esposa, empreendedora, gestora de negócios e criadora do revolucionário método de drenagem corporal, Método Renata Mattos.
Renata viveu nos EUA onde iniciou seus estudos em massagem e estética, em Cambridge - MA, estudou inglês em Harvard, retornou ao Brasil por seis anos, se atualizou e se especializou em drenagem linfática e pós-operatório. Depois de muita dedicação, esforço, perseverança, tenacidade e estudo de mercado; Renata, pioneira e empreendedora, resolveu conhecer e explorar a Nova Ze-

Renata Mattos com suas alunas
lândia, onde vive ha 7 anos.







Sua historia na Nova Zelândia foi bem interessante, um pequeno país de 5 milhões de habitantes, onde não sabiam absolutamente nada sobre drenagem linfática e seus benefícios. Renata iniciou em um luxuoso bairro do centro histórico da cidade mais movimentada da ilha, em uma localização estratégica. Primeiro, conquistou o público brasileiro; “O boca a boca foi o que me trouxe até onde estou hoje”, diz Renata, referindo-se ao público brasileiro que também precisava desesperadamente deste serviço. Logo ela foi apresentada aos melhores médicos da cidade, que começaram a encaminhá-la pacientes de pós-operatório.

Após dois anos, Renata quadruplicou seu faturamento e ampliou para uma clínica três vezes maior. Renata então começou a sentir uma grande necessidade de formar profissionais com a técnica unificada em sua clínica; foi quando no ano de 2019 seu método foi colocado no papel em forma de curso para profissionais em sua clínica. Em 2020 a empreenderoda, sentiu que poderia ter suas “mãos” em outras clínicas pelo país, o seu objetivo era qualificar, principalmente, a profissional brasileira; visando que a técnica criada (Método Renata Mattos) e as massagens oferecidas em sua clinica, se tornassem uma referência da beleza brasileira. A grande procura, pelos profissionais locais, brasileiros ou nao, em aprender sobre a “massagem genuinamente brasileira” manuseada com a metodologia RM, que apresenta resultados na primeria sessao, fez mais uma vez, com que a visionaria empresaria, Renata Mattos buscasse novos horizontes para seguir crescendo, expandindo seus conhecimentos e capacitando profissionais.
Em uma de suas férias ao EUA para visitar seu filho mais velho, residente no país, Renata foi convidada a ministrar seu curso, o que a despertou para voos mais altos. Seus planos são vir aos Estados Unidos com mais frequência para ver seu filho e compartilhar seu conhecimento e experiência com a comunidade. Se você deseja conhecer mais sobre


SPONSORS


o trabalho da Renata Mattos, acesse: www.azaleaurbanspa.com - @ azaleaurbanspa – se preferir, envie um e-mail para receber mais informações sobre o Curso de Drenagem Linfática com o Método Revolucionário RM para: info@azaleaurbanspa.com






























Fort Lauderdale é uma cidade encantadora localizada na Flórida, que tem muito a oferecer aos turistas que a visitam. Desde suas belas praias até sua vibrante cena cultural, Fort Lauderdale é uma cidade que cativa todos que a visitam. Uma das principais atrações da cidade são suas praias. Com mais de 37 quilômetros de costa, Fort Lauderdale oferece uma ampla variedade de praias para todos os gostos. Desde praias movimentadas com bares e restaurantes até praias mais tranquilas e isoladas, há opções para todos os tipos de viajantes. Algumas das praias mais populares incluem a Fort Lauderdale Beach, a Hollywood Beach e a Dania Beach.



Fort Lauderdale Beach é uma das praias mais famosas e populares da cidade. Com sua areia branca e fina, águas cristalinas e uma grande variedade de atividades, é um destino imperdível para todos que visitam a cidade.
A praia é bastante movimentada, especialmente durante os meses de verão, mas há espaço suficiente para todos. Há muitas opções de estacionamento disponíveis, embora algumas áreas possam ser mais caras e disputadas durante os horários de pico.
A praia é bem cuidada e limpa, com várias opções de serviços, incluindo restaurantes, bares e lojas ao longo do calçadão. Há muitas atividades para se fazer na praia, como alugar cadeiras e
Hollywood Beach é outra praia incrível. Ela é famosa por sua faixa de areia branca e suas águas cristalinas, além de oferecer muitas opções de entretenimento e lazer para os visitantes. Uma das principais atrações de Hollywood Beach é o calçadão que se estende por mais de 3 quilômetros ao longo da praia. O calçadão é perfeito para caminhar, correr, andar de bicicleta ou simplesmente sentar e apreciar a paisagem. Há muitas opções de restaurantes, bares e lojas ao longo do calçadão, bem como atividades como aluguel de bicicletas, cadeiras de praia e guarda-sóis.
A praia em si é bem cuidada e oferece muitas opções de atividades aquáticas, como passeios de barco, jet ski e parasailing. Além disso, há muitos

guarda-sóis, praticar esportes aquáticos, como stand-up paddle e jet ski, ou simplesmente relaxar e aproveitar o sol.

Uma das características mais marcantes da Fort Lauderdale Beach é a sua grande quantidade de hotéis e resorts, que oferecem vistas deslumbrantes da praia e do mar. Alguns hotéis oferecem também serviços de spa, restaurantes, bares e outras atividades.
Para quem deseja um pouco mais de tranquilidade, é possível caminhar para o norte ou para o sul da praia e encontrar áreas menos movimentadas e mais calmas, ideais para quem quer se desconectar e aproveitar o ambiente natural.
salva-vidas na praia para garantir a segurança dos banhistas.
Outra atração popular de Hollywood Beach é o Hollywood Beach Broadwalk, um calçadão pavimentado com vista para a praia. O calçadão tem muitas opções de restaurantes e bares, além de lojas de souvenirs e boutiques. O Hollywood Beach Theater também está localizado no calçadão e oferece uma programação variada de shows e eventos.
Para quem gosta de natureza, é possível fazer uma caminhada até o Anne Kolb Nature Center, um parque natural com muitas trilhas para caminhada e observação de pássaros. Há também uma grande variedade de peixes e vida selvagem para serem observados nas lagoas e canais do parque.
Outra atração imperdível é o Riverwalk Fort Lauderdale, um destino turístico popular que oferece uma bela área verde e espaço para caminhar e apreciar as vistas do rio New River, localizado no centro de Fort Lauderdale.
O Riverwalk tem cerca de 3 quilômetros de extensão, e ao longo do caminho, você encontrará uma grande variedade de lojas, restaurantes, bares e outras atrações turísticas. Algumas das principais atrações do Riverwalk incluem o Museum of Discovery and Science, o Broward Center for the Performing Arts e o Fort Lauderdale Historical Society Museum.
O Riverwalk também oferece muitas opções de atividades ao ar livre, como passeios de barco, pesca, caiaque e stand -up paddle. Para quem gosta de

ciclismo, há muitas ciclovias e trilhas para bicicletas ao longo do caminho.
Uma das características mais marcantes do Riverwalk é sua arquitetura e design urbano. Ao caminhar pelo Riverwalk, você verá muitos edifícios modernos e históricos, além de várias pontes que cruzam o rio New
O Museum of Discovery and Science é um museu interativo localizado em Fort Lauderdale. Ele é um destino popular para famílias com crianças e oferece uma variedade de exposições interativas e programas educacionais.
O museu abriga mais de 200 exposições interativas em seus dois andares, incluindo exposições sobre o oceano, a vida selvagem da Flórida, a tecnologia e a história da aviação. Há também uma grande tela de cinema IMAX 3D que exibe filmes educacionais sobre a natureza e a ciência.
Uma das exposições mais populares do museu é o EcoDiscovery
Center, que ensina sobre a importância da preservação do meio ambiente e inclui uma exibição sobre a vida marinha da Flórida. Outra exposição popular é o Prehistoric Florida, que explora a história geológica da Flórida e apresenta fósseis de animais pré-históricos encontrados na região.


River.
O Riverwalk é um ótimo lugar para passar um dia agradável ao ar livre com amigos e familiares, especialmente durante os meses de clima ameno na Flórida. Há muitas áreas de piquenique e espaços para sentar e apreciar as vistas do rio.












O museu também oferece programas educacionais e eventos especiais ao longo do ano, incluindo oficinas de ciência para crianças, aulas de culinária, palestras e apresentações ao vivo.
O NSU Art Museum Fort Lauderdale é um museu de arte localizado no centro de Fort Lauderdale, na Flórida. Fundado em 1958, o museu abriga uma coleção de mais de 7.000 obras de arte, incluindo pinturas, esculturas, fotografias e obras de arte em mídia mista.
A coleção do museu inclui obras de arte de artistas renomados como Pablo Picasso, Henri Matisse, Diego Rivera, Frida Kahlo, Salvador Dalí, Roy Lichtenstein e muitos outros artistas contemporâneos.
O museu também abriga exposições temporárias de arte contemporânea de artistas locais, nacionais e
internacionais. Além disso, o museu oferece uma variedade de programas educacionais, incluindo palestras, oficinas e passeios pelo museu.
Além disso, o Museu de Descoberta e Ciência abriga um simulador de voo que permite aos visitantes experimentarem a emoção de pilotar um avião em um ambiente seguro e controlado.

O NSU Art Museum Fort Lauderdale está localizado em um edifício moderno de três andares projetado pelo arquiteto Edward Larrabee Barnes. O edifício é conhecido por sua fachada de vidro e seu design contemporâneo, que combina perfeitamente com as exposições de arte contemporânea que o museu abriga.
Uma das exposições mais populares do museu é a coleção permanente de arte americana moderna e contemporânea, que inclui obras de artistas americanos importantes, como Robert Rauschenberg, Andy Warhol e Jasper Johns.










Quem pretende passar férias em Orlando, tem a opção de alugar casas próximo à praia. O empresário João Borracheiro, bastante conhecido na comunidade brasileira em Massachusetts, com apoio de sua filha Beatriz Souza, fez uma parceria com a corretora Elizandra Aguiar, e colocou suas casas para alugar. São imóveis de luxo que ficam a apenas 20 minutos da Disney.
São casas de 5 e 8 quatros, com até sete banheiros, piscinas, jacuzzi, televisão em todos os quartos, máquina de lavar e secar, garagem para dois carros e mais dois no driveway.
Quem aluga ainda tem direito ao um lindo clubhouse em frente das casas com academia, cafeteria, sala de jogos, lanchonete e restaurante, tobogã, piscina, lazer, quadra de basquete, futebol e vôlei.
Para saber mais sobre a disponibilidade dos imóveis, ligue nos Telefones (857) 800-4159, com Elizandra Aguiar, ou (781) 333-7170, com Beatriz Souza.


















INGREDIENTES

• 2 kg de costela bovina
• Sal grosso a gosto
• Pimenta-do-reino a gosto
• Papel alumínio
MODO DE PREPARO
















lucianosodre@brazilian�mes.com


























Lave a costela em água corrente e seque com papel toalha.
Tempere com sal grosso e pimenta-doreino a gosto, esfregando bem em toda a carne.
Enrole a costela com papel alumínio, formando um pacote bem fechado.
Leve a costela para assar em fogo baixo (entre 120°C e 150°C) por cerca de 5 horas.



Olá pessoal, hoje preparei duas receitas para tornar o seu final de semana ainda mais saboroso. Que tal uma costela no bafo, daquelas que desmancham e nem precisa de faca para cortar ou que tal fazer aquele entrevero diferenciado? recheio
INGREDIENTES
• 500g de carne bovina em cubos (preferencialmente contrafilé)
• 500g de linguiça calabresa fatiada
• 2 cebolas grandes em rodelas
• 2 pimentões (verde e vermelho) em tiras
• 4 dentes de alho picados


MODO DE PREPARO
• 1 colher de sopa de azeite de oliva
• Sal e pimenta-do-reino a gosto
Em uma panela grande ou churrasqueira, aqueça o azeite em fogo médio. Adicione a carne e deixe dourar por alguns minutos, mexendo de vez em quando. Acrescente a linguiça e continue mexendo até que ela comece a dourar.
Adicione as cebolas, os pimentões e o alho, e refogue tudo por mais alguns minutos até que os legumes fiquem macios. Tempere com sal e pimenta-do-reino a gosto, mexa bem e sirva.
O entrevero é uma ótima opção para servir com arroz e salada, ou até mesmo como recheio de um sanduíche. Bom apetite!

Após esse tempo, retire a costela do papel alumínio e deixe-a mais alguns minutos na churrasqueira para dourar. Pronto! Sua costela no bafo está pronta para ser saboreada. Aproveite!

































































Aries 21/03 A 20/04
Você terá a oportunidade de expressar os seus sentimentos, e isso é muito positivo para o seu desenvolvimento, mas, ao mesmo tempo, traz ansiedade. Expressar o que você pensa é positivo e lembre-se de que tudo bem não agradar a todos. Você está em processo de crescimento e se encaixando com a sua verdade

Touro 21/04 A 20/05
Em maio, uma escolha financeira é necessária. Isso pode envolver negociações e experiências que não estão totalmente sob o seu controle. Tome cuidado com a ansiedade, porque de alguma forma você terá que se comunicar de uma forma assertiva, mas evite atitudes impulsivas.

Gêmeos
21/05 A 20/06
Você está desenvolvendo um projeto que te faz muito feliz, mas ao mesmo tempo existe ansiedade porque há um tema financeiro a ser resolvido. O céu pede calma, porque soluções criativas estão a caminho. Faça a sua parte, com uma pesquisa mais detalhada. Mas pode ter certeza de que esse projeto vai sair do papel.

Câncer
21/06 A 20/07
Em maio, um convite profissional muito interessante poderá acontecer. Esse mesmo cenário pode se tratar de movimentos discretos que acontecem dentro da organização. O fato é que vêm novidades por aí. Busque se municiar com todas as informações necessárias e evite a impulsi- vidade. É preciso examinar antes de tomar uma decisão.

Leão 21/07 A 22/08
Você pode receber um convite para um evento do qual você deseja mui- to participar. É um mês agradável para se relacionar com os seus amigos. Essa experiência pode envolver uma viagem ou um curso. Mas tome cuidado com a ansiedade. É preciso antes observar para entender o que ocorre à sua volta. Você pode se sentir ansioso.

Virgem 23/08 A 22/09
Maio traz soluções financeiras envolvendo acertos de contas e investimentos para desenvolver as suas metas. Mas é preciso evitar qualquer decisão impulsiva. Você está ansioso, e isso pode envolver relações com amigos ou um projeto específico. Você também pode ser reconhecido pela chefia ou receber uma premiação.

Libra 23/09 A 22/10
Uma pessoa lhe traz boas notícias neste mês, mas está com pressa para tomar uma decisão importante. Maio é um bom mês para se colocar no lugar do outro e entender o que se passa. Esse mesmo cenário favorece o relacionamento amoroso. Existe um cenário que está sendo encerrado, mas é preciso saber transitar até o desfecho.

Escorpião 23/10 A 21/11
Uma decisão deve ser tomada no seu trabalho. O céu traz soluções que podem envolver investimentos. Dedique maio para organizar a sua agenda ou as atividades que fazem parte da sua rotina. Uma nova proposta de trabalho pode surgir.

Sagitário 22/11 A 21/12
É um mês ótimo para o namoro. O céu colabora com declarações de amor e uma decisão a dois pode ser tomada. Esse mesmo cenário pode mexer com experiências destinadas aos filhos. Veja o que se adequa à sua realidade. Mas tome cuidado com a pressa e com questões que não estão totalmente sob o seu controle.

Capricórnio 22/12 A 20/01
Um movimento em família ou direcionado a um imóvel o deixa muito feliz. Essa experiência toca favoravelmente a sua rotina, mas também traz embates com uma pessoa muito próxima. A pessoa tocada pode estar ansiosa e com pressa para resolver uma situação. É preciso ter calma.

Aquário 21/01 A 19/02
Maio traz boas novas que podem envolver as relações próximas, mas também pode se tratar de uma declaração de amor. A sua autoestima está sendo mexida favoravelmente. Mas é preciso tomar uma decisão rápida, que pode mexer com a sua rotina ou o seu trabalho.

Peixes 20/02 A 20/03
Existe uma decisão financeira importante, que vem com o objetivo de favorecer a família ou que po- de se tratar de um imóvel. É uma notícia boa e que mexe com você. Mas essa experiência pede sabedoria, porque traz também muita ansiedade. Por isso tenha calma, porque, ao longo do dia, essa situação se desdobrará.







Texto de Lia Carminati


decisão de comprar um imóvel é uma das decisões mais importantes de nossas vidas. Sabemos que o investimento financeiro e o processo de se preparar para esse passo importante da vida, exige mudanças de comportamento e muitas vezes até sacrifícios e nem todos estão dispostos a fazer. Sem falar no valor afetivo e todas as emoções que o processo irá exigir de cada comprador.



A falta de informação é, na maioria das vezes o fator que impossibilita muitos a realizarem esse sonho. Muitas pessoas desconhecem o processo que precisam traçar para se qualificar para o financiamento de um imóvel, e por essa razão acreditam que não conseguem e desistem
ADVERTISING
as dúvidas, auxiliar os leitores a caminhar com segurança e sem medo até o sonho da casa própria.







antes mesmo de tentar!

A nossa coluna tem a missão de trazer informação para a comunidade brasileira e o objetivo de desmistificar, esclarecer






by radius nancial group inc., NMLS #1846. CT

17213 FL Lender/Servicer
MLD309/ MLD1562 MA Lender/Broker MC1846 NH 7986-MB RI Licensed Lender/Broker 20031544LL/20183611LB SC MLS-1846









O café com Real Estate estará a cada 15 dias trazendo tópicos importantes para empoderar, encorajar e auxiliar no que for possível, todos os leitores a darem os passos necessários para saírem do aluguel.











saírem do aluguel.



Além de ser um canal de informação, queremos trazer tópicos de curiosidade como falar sobre estilos das propriedades, tendências, mudanças no mercado. Valores e custos de uma compra e tudo mais que os leitores quiserem, desejarem e



UM INOVADOR E EXCLUSIVO PROGRAMA DE COMPRA E REFINANCIAMENTO





Você não precisa mais esperar o mercado mudar ou as taxas de juros baixarem para se sentir seguro para comprar sua casa
diga olá ao radius Free-Fi Program


O programa “FreeFi” da Radius permite que você re nancie a qualquer momento dentro de 3 anos do fechamento. Este certi cado não é uma promessa de empréstimo. *O re nanciamento deve ser iniciado por você e está sujeito a eligibilidade, bem como aos termos e condições do programa.




Essa é a oportunidade de comprar a sua casa agora e refinanciar quando as taxas de juros cairem, sem precisar pagar os custos de fechamento da Radius novamente, o que vai te economizar muito dinheiro no futuro.

























pedirem sobre a área imobiliária.
É um canal aberto, entre você e eu! Como sentar em uma mesa de café e bater um papo informativo mas cheio de valor e com muito amor! Vai ser um prazer tomar esse café com vocês!

